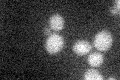
YJL094C
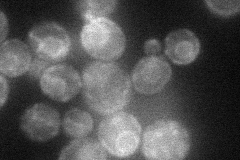
YJL094C
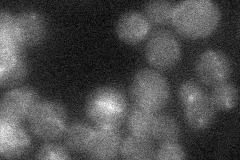
YJL094C
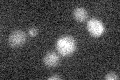
YJL094C

View description
Putative K+/H+ antiporter with a probable role in intracellular cation homeostasis, localized to Golgi vesicles and detected in highly purified mitochondria in high-throughput studies
Localization:
Intensity:
Fold change:
Significance:
-
C’ GFP library in SD
below threshold17.24 -
N' NOP1pr-GFP in SD
ER36.8242 -
N' TEF2pr-mCherry in SD

ER23.4652 -
N' NATIVEpr-GFP in SD
below threshold16.6613 -
N' TEF2pr-VC and Cyto-VN in SD

below threshold22.9487 -
C’ GFP library in SD+DTT

cytosol14.430.83No -
C’ GFP library in SD+H2O2

cytosol14.040.81No -
C’ GFP library in Starvation Media
cytosol15.680.9No -
C’ GFP library on the background of Pup2-DaMP

below threshold -
C’ GFP library on the background of CCT mutant

below threshold13.81330.800784No
